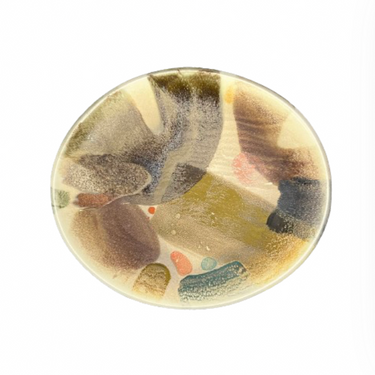
Rio Abricó Platter, Extra Large

Filter and sort 15 products
Get To Know Us
For over 40 years, AnnSandra has been the preeminent destination for bridal registry, high-end giftware, luxury tabletop and distinctive home décor. AnnSandra offers an artfully curated collection, including legacy brands like Baccarat, Bernardaud, and William Yeoward, alongside the latest most coveted brands like L’Objet, Aerin, and Tina Frey, among many others. Whether you're shopping with us online, over the phone or visiting us by appointment at our showroom, we pride ourselves on unmatched, exceptional, customer service.
Recently Viewed Products
Our Favorites For A Reason
Discover our best-selling styles.